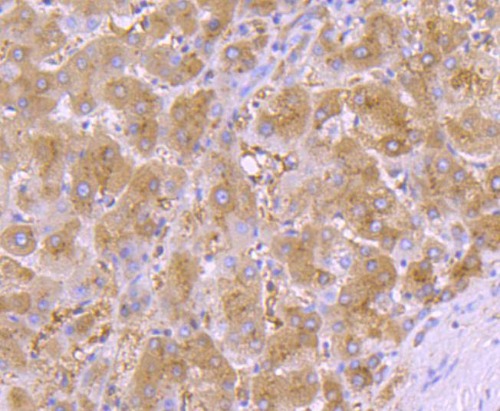

AAT Rabbit Monoclonal Antibody(ARA901)
CAT.NO. : ARA6736
RMB Please choose
RMB Please choose
Size:
Trail, Bulk size or Custom requests Please contact us
*产品价格可能会有所调整,请以品牌方官网实时更新的价格为准,以确保准确性。
Background
Alpha-1 antitrypsin or α1-antitrypsin (A1AT, α1AT, A1A, or AAT) is a protein belonging to the serpin superfamily. It is encoded in humans by the SERPINA1 gene. A protease inhibitor, it is also known as alpha1–proteinase inhibitor (A1PI) or alpha1-antiproteinase (A1AP) because it inhibits various proteases (not just trypsin). A1AT is a 52-kDa serpin and, in medicine, it is considered the most prominent serpin; the terms α1-antitrypsin and protease inhibitor (Pi) are often used interchangeably. Most serpins inactivate enzymes by binding to them covalently. These enzymes are released locally in relatively low concentrations where they are immediately cleared by proteins such as A1AT. Besides limiting elastase activity to limit tissue degradation, A1PI also acts to induce locomotion of lymphocytes through tissue including immature T cells through the thymus where immature T cells mature to become immunocompetent T cells that are released into tissue to elevate immune responsiveness. Like all serine protease inhibitors, A1AT has a characteristic secondary structure of beta sheets and alpha helices. Mutations in these areas can lead to non-functional proteins that can polymerise and accumulate in the liver (infantile hepatic cirrhosis).
Application
Application |
Dilution Ratio |
IHC-P |
1:50-1:200 |
Overview
Immunogen |
Recombinant protein within Human alpha 1 Antitrypsin aa 1-418 / 418 |
Species Reactivity |
Human |
Validated Applications |
WB, IF-Cell, IF-Tissue, IHC-P, IP |
Molecular Weight |
Predicted band size: 47 kDa |
Positive Control |
Human spleen tissue lysates, MCF-7, Hela, HepG2, human spleen tissue, human liver tissue, human breast carcinoma tissue |
Conjugation |
unconjugated |
RRID |
AB_3073467 |
Form |
Liquid |
Concentration |
1ug/ul |
Storage Buffer |
1*TBS (pH7.4), 0.05% BSA, 40% Glycerol. Preservative: 0.05% Sodium Azide |
Isotype |
IgG |
Purification Method |
Protein A affinity purified |
Data
Immunohistochemical staining of human liver tissue sections using AAT Rabbit Monoclonal Antibody (ARA901).

Immunohistochemical staining of human spleen tissue sections using AAT Rabbit Monoclonal Antibody (ARA901).

Immunohistochemical staining of human breast carcinoma tissue sections using AAT Rabbit Monoclonal Antibody (ARA901).
Storage
Store at 4°C short term. For long term storage, store at -20°C, avoiding freeze/thaw cycles.
Research Use Only
For Research Use Only. Not for use in diagnostic procedures.
